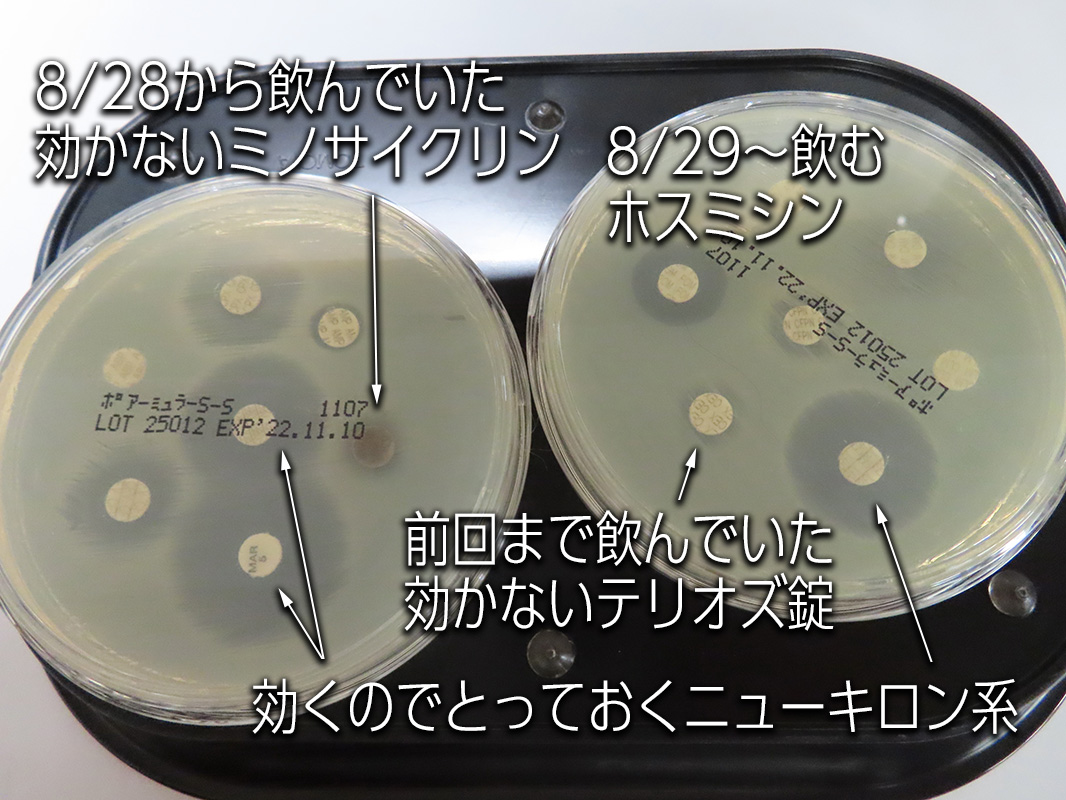
ファイル 8396-1.jpeg

4歳すぎてから続けて4回も膀胱炎になてしまっている“もに”(´Д⊂グスン
【1回目の膀胱炎】は2022年7月26日から
【2回目の膀胱炎】は2022年8月5日から
【3回目の膀胱炎】は2022年8月28日から
【4回目の膀胱炎】は2022年9月26日から
【4回目の膀胱炎】で9月26日から21日間、飲み続けた抗生剤(ホスミシン)と胃のためのレパミピドを、今朝飲み終えました。
培養検査をして効くことがわかっている抗生剤を飲んでいるあいだは安心でしたが
飲み終えてこれからが正念場!
今後は獣医師専用サプリのUTクリーンと
獣医師専用の処方フード『ユリナリーS/O』で頑張ります!
数日前から手作りご飯とふやかしたフードを半々にし、今日からはフードが3分の2で、手作りご飯は3分の1。
もう少ししたら、フードにちょっとお惣菜をトッピングする感じまでフードを増やし、それを1週間くらい続けて
薬が終わった2週間後の10月31日に検尿します。
その間に、処方フードに近い『マグネシウム、リン、(タンパク質)』をへらした手作りごはんのレシピを考えてくれるそうです。
とにかく今度こそなんとしても治してあげないと!!!
おやつはカリカリのままのド『ユリナリーS/O』を主にあげていますが、
9月30日から始まった石焼き芋やちょっとのあいばろおやつは食べてもいいことにしています。
お楽しみは必要ですからね(●^_^●)
こんなの(栗まんじゅう)も獣医さんに内緒でほんのちょっとだけね(*^-^*)
だって、美味しいものは(ほんのちょっとだけだけど)味あわせてあげたくなっちゃうんですものぉヾ(@^(∞)^@)ノゴチソウサマデシタ♪